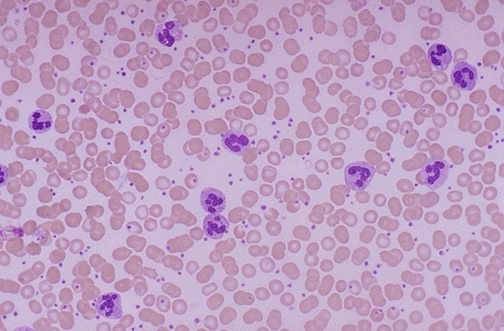

. |
|||
|
| Principal | Atlas de Patología | Inflamación | |
www.Caninum.com |
||
|
Patología General |
|||
|
| Homepage | Tarjetas | Foro y Clasificados | Mascotas | Servicios | Informes Veterinarios | | Textos Caninum | Guía de Veterinarias | Guía de Criaderos | Contáctenos |
|
|||